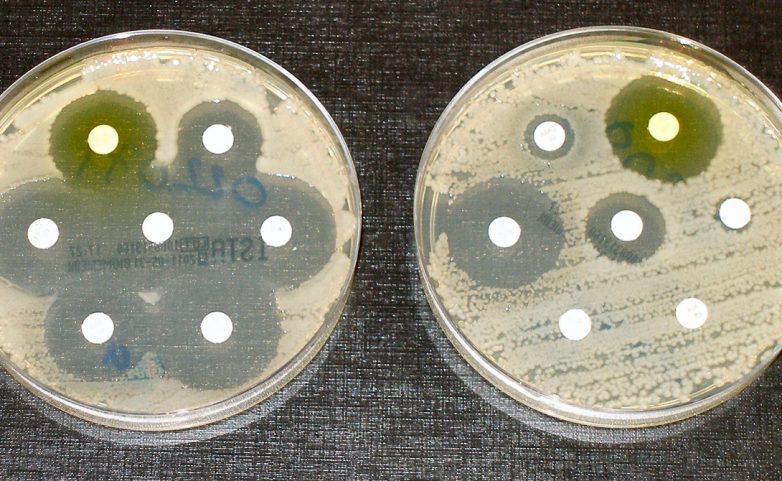

Эпидемии, которые могут стереть человечество с лица земли
Менее ста лет назад 50 миллионов человек погибло от пандемии гриппа. С тех пор планета стала несколько более людной — а значит, более подверженной вирусным заболеваниям, которые передаются от особи к особи. Эти пять пандемий уже случились в прошлом и вполне способны вернуться к нам завтра.

Испанка возникла где-то во время Первой мировой войны и уничтожила 50 миллионов человек по всей планете. Многие погибали спустя всего пять часов после заражения. К началу 20-х годов пандемия сошла на нет, но навсегда ли? Вряд ли. Вспомните птичий грипп 2000-х? А свиной грипп, поразивший людей всего несколько лет назад? Все это — вариации испанского гриппа, что очень беспокоит специалистов.
Вирусы вроде испанского гриппа не имеют монополии на уничтожение человечества. Те же бактерии тоже стремятся урвать свой кусок пирога. И самое забавное, что чем больше мы стараемся уничтожить опасные бактерии, тем сильнее они становятся. Вот, как это происходит: доза антибиотиков введенная человеку или животному убивает большую часть вредоносных бактерий — но некоторые, с каким-то генетическим дефектом, выживают и мутируют, становясь сильнее. Уже их потомство получает иммунитет от последнего поколения лекарств и существует до тех пор, пока не погибнет от более сильного антибиотика. И все бы хорошо, вот только врачи опасаются, что рано или поздно бактерии выведут вид полностью резистентный от антибиотиков в принципе. Это может стать началом конца всего человечества.

К началу 2003 года респираторные маски были в большой моде. Вспышка SARS ударила по Торонто, проделав неблизкий путь из Азии. К 2004 году по всему миру погибло всего 10 000 человек и все прекратилось — так, по крайней мере, казалось врачам. И вот, спустя несколько лет, атипичная пневмония вернулась, серьезно обеспокоив ученых всего мира. Отчеты из Мекки показали, что новый, мутировавший вирус (MERS) появился во время паломничества людей к священному месту. В следующем году Хадж вполне может инициировать новую вспышку атипичной пневмонии, которая разнесется по всему миру вместе с религиозными паломниками.

Да, эта ужасная болезнь косила человечество еще в средние века — но это не значит, что можно не опасаться ее сегодня. Такие болезни не уходят бесследно, они просто временно скрываются за кулисами, готовые в любой момент устроить новую пляску смерти. И не пугайтесь, но чума вернулась уже сейчас. В прошлом году на Мадагаскаре погибло более тысячи человек — заразу, как и в далеком прошлом, переносят крысы.

Пандемии не отправляют предупреждающих писем, прежде чем накинуться на человечество. Прогнозировать их очень трудно. Но ученые уверены — новая напасть наверняка придет к нам от животных. Эксперты полагают, что следующая глобальная пандемия будет вызвана вирусом с высокой способностью к мутации. Он будет рекомбинировать элементы своего генетического материала в процессе репликации. То есть, прежде чем ученые остановят распространение вируса, пройдет немало времени, купленного кровью всего человечества.
Возвращение испанки

Испанка возникла где-то во время Первой мировой войны и уничтожила 50 миллионов человек по всей планете. Многие погибали спустя всего пять часов после заражения. К началу 20-х годов пандемия сошла на нет, но навсегда ли? Вряд ли. Вспомните птичий грипп 2000-х? А свиной грипп, поразивший людей всего несколько лет назад? Все это — вариации испанского гриппа, что очень беспокоит специалистов.
Пандемия резистентных бактерий
Вирусы вроде испанского гриппа не имеют монополии на уничтожение человечества. Те же бактерии тоже стремятся урвать свой кусок пирога. И самое забавное, что чем больше мы стараемся уничтожить опасные бактерии, тем сильнее они становятся. Вот, как это происходит: доза антибиотиков введенная человеку или животному убивает большую часть вредоносных бактерий — но некоторые, с каким-то генетическим дефектом, выживают и мутируют, становясь сильнее. Уже их потомство получает иммунитет от последнего поколения лекарств и существует до тех пор, пока не погибнет от более сильного антибиотика. И все бы хорошо, вот только врачи опасаются, что рано или поздно бактерии выведут вид полностью резистентный от антибиотиков в принципе. Это может стать началом конца всего человечества.
Ближневосточный респираторный синдром

К началу 2003 года респираторные маски были в большой моде. Вспышка SARS ударила по Торонто, проделав неблизкий путь из Азии. К 2004 году по всему миру погибло всего 10 000 человек и все прекратилось — так, по крайней мере, казалось врачам. И вот, спустя несколько лет, атипичная пневмония вернулась, серьезно обеспокоив ученых всего мира. Отчеты из Мекки показали, что новый, мутировавший вирус (MERS) появился во время паломничества людей к священному месту. В следующем году Хадж вполне может инициировать новую вспышку атипичной пневмонии, которая разнесется по всему миру вместе с религиозными паломниками.
Бубонная чума

Да, эта ужасная болезнь косила человечество еще в средние века — но это не значит, что можно не опасаться ее сегодня. Такие болезни не уходят бесследно, они просто временно скрываются за кулисами, готовые в любой момент устроить новую пляску смерти. И не пугайтесь, но чума вернулась уже сейчас. В прошлом году на Мадагаскаре погибло более тысячи человек — заразу, как и в далеком прошлом, переносят крысы.
Неизвестная пандемия

Пандемии не отправляют предупреждающих писем, прежде чем накинуться на человечество. Прогнозировать их очень трудно. Но ученые уверены — новая напасть наверняка придет к нам от животных. Эксперты полагают, что следующая глобальная пандемия будет вызвана вирусом с высокой способностью к мутации. Он будет рекомбинировать элементы своего генетического материала в процессе репликации. То есть, прежде чем ученые остановят распространение вируса, пройдет немало времени, купленного кровью всего человечества.
Только зарегистрированные и авторизованные пользователи могут оставлять комментарии.
0
Если грызуны будут опять переносчиками заразы, то человеку тоже следует принять меры, свалки надо очищать не мусорить, чтобы крысы не плодились в городах и селах, все от грязи, отходов элементарной не чистоплотности…
- ↓
0
«Слухи о моей смерти сильно преувеличенны». Страшилка.
- ↓
+1
Каких еще новых болезней ждать человечеству… все эти напасти мутируют, приспосабливаются, так что, микробиологам и эпидемиологам работы хватит и даже более…
- ↓
0
Конечно, если бы они меньше работали, то глядишь бы и не появлялись бы новые болезни из старых.
- ↑
- ↓
+1
Каких еще новых болезней ждать человечеству…
- ↓
+1
С учётом высокой мобильности и плотности населения последствия практически любой эпидемии, особенно с длительным латентным периодом для человечества будут фатальными. Безусловно люди выживут, но вопрос в каком количестве.
- ↓
0
вот именно в каком количестве? конечно, те кто выводит новые болезни имеет от них и лекарства, но нам 6 миллиардам их не дадут, так как мы лишние на этой планете по мнению мирового правительства.
- ↑
- ↓
-5
Фу Фу ФУ
- ↓
0
Не стоит оставлять надежду, что современная мировая наука придумает, как обеспечить жизнь человека в борьбе с новыми вызовами смертельных опасных болезней…
- ↓

